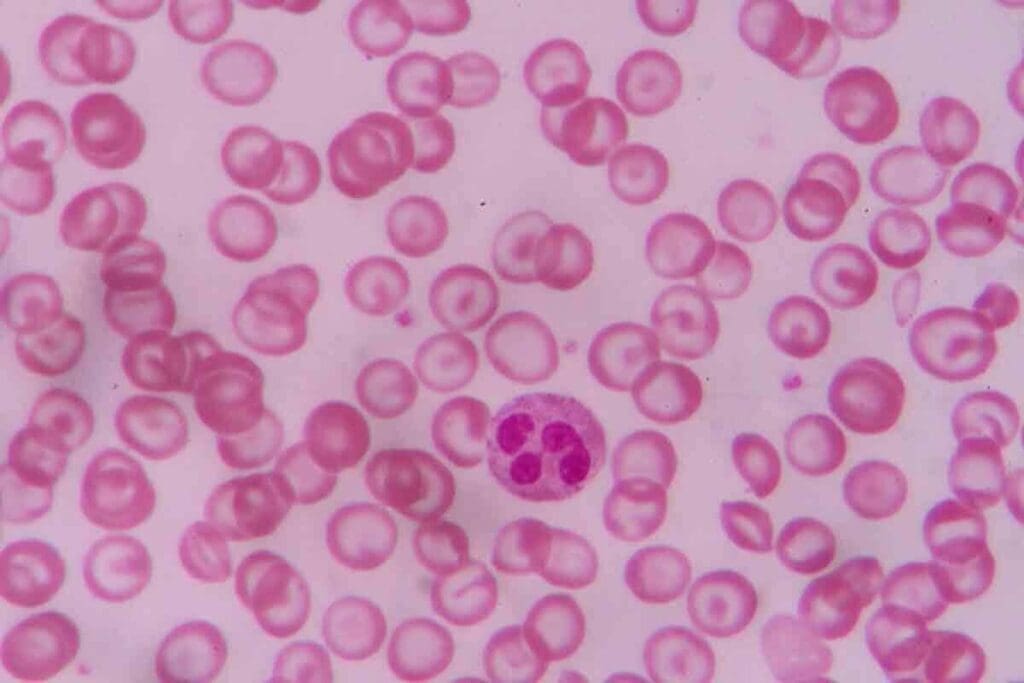
How Much Blood Loss Causes Anemia? 2 image 2662 LIV Hospital

Last Updated on November 14, 2025 by Ugurkan Demir

Losing a lot of blood can cause anemia, a condition where you have fewer red blood cells. This can happen suddenly or over time, based on how much and for how long you lose blood. At Liv Hospital, we know how important it is to figure out when blood loss leads to anemia.
When you lose a lot of blood fast, it can cause sudden anemia. You might feel your heart beating too fast or your blood pressure dropping. Understanding how much blood loss causes anemia is crucial; generally, losing more than 20% of your blood volume can lead to symptoms, and loss beyond 40% is life-threatening. At our facility, we offer detailed care, including custom treatment plans and new medical solutions for those with anemia caused by significant blood loss.
Key Takeaways
- Significant blood loss can lead to acute or chronic anemia.
- Losing more than 15% of blood volume can cause symptoms like tachycardia and hypotension.
- Liv Hospital offers personalized treatment plans for anemia patients.
- Understanding the threshold for significant blood loss is key to effective management.
- Comprehensive care includes innovative medical solutions for anemia from blood loss.
Understanding Anemia and Its Relationship to Blood Loss
Blood loss can cause anemia, a condition where there are not enough red blood cells. This leads to a lack of oxygen in the body. Knowing about anemia helps us see how blood loss affects it.
What Is Anemia?
Anemia is when there are fewer red blood cells or less hemoglobin in the blood. Hemoglobin carries oxygen to the body’s parts. Without enough oxygen, tissues and organs don’t get enough oxygen, causing health problems.
Symptoms of anemia include tiredness, weakness, pale skin, and shortness of breath. Severe cases can lead to heart issues.
The Role of Red Blood Cells and Hemoglobin
Red blood cells are key in delivering oxygen. They have hemoglobin that picks up oxygen in the lungs and releases it. This is vital for the body’s organs to work properly.
The body constantly makes new red blood cells. But blood loss can make the demand for them higher than the supply, causing anemia.
Different Causes of Anemia
Anemia can come from:
- Blood loss: Losing blood can lower red blood cells.
- Nutritional deficiencies: Not getting enough iron, vitamin B12, or folate can stop red blood cells from being made.
- Chronic diseases: Some long-term conditions can affect red blood cell production or cause anemia.
- Genetic disorders: Certain genetic conditions can impact red blood cell production or function.
Knowing these causes helps in diagnosing and treating anemia. For blood loss, finding and quickly managing the source is vital to prevent anemia.
How Much Blood Loss Causes Anemia?

Finding out how much blood loss leads to anemia is tricky. It depends on many things,l ike health and how well the body can make new red blood cells. Losing too many red blood cells or not making enough can cause anemia.
Quantifying Blood Loss and Anemia Development
It’s hard to say exactly how much blood loss causes anemia. Losing over 40% of blood is very serious. But anemia symptoms can show up when hemoglobin levels fall to 7 to 8 g/dL. How well the body can make new red blood cells also matters a lot.
The 15% Threshold: When Symptoms Begin
Studies show that losing about 15% of total blood can start to show symptoms. At this point, the body might not show big signs of anemia yet. But you might start to feel tired and weak. Losing more blood than this can make symptoms worse.
Individual Factors Affecting Susceptibility
Many things can make some people more likely to get anemia from blood loss. These include health, other medical conditions, diet, and how well the body can make new red blood cells. For example, people with iron or vitamin deficiencies might get anemia more easily.
| Factor | Influence on Anemia Susceptibility |
| Overall Health | Poor health can increase susceptibility |
| Nutritional Status | Iron and vitamin deficiencies can exacerbate anemia |
| Presence of Chronic Diseases | Conditions like kidney disease can affect red blood cell production |
Knowing about these factors helps catch anemia early. Healthcare providers can then act fast to stop anemia from getting worse. This is important for people at higher risk.
Acute vs. Chronic Blood Loss Anemia
It’s important to know the difference between acute and chronic blood loss anemia. This is because they need different treatments. Blood loss occurs when you lose a lot of red blood cells. This can happen quickly or slowly over time.
Defining Acute Blood Loss Anemia
Acute blood loss anemia happens fast after a big bleed. It’s often seen after injuries, surgeries, or severe accidents. The body tries to keep oxygen flowing to important parts right away.
“Acute blood loss anemia requires immediate attention to stabilize the patient and address the underlying cause of bleeding.”
Symptoms can be serious, like feeling dizzy, fainting, or having trouble breathing. Quick medical help is needed to avoid more problems.
Understanding Chronic Blood Loss Anemia
Chronic blood loss anemia builds up slowly over time. It’s caused by things like stomach ulcers, heavy periods, or some cancers. As one doctor said,
“Chronic blood loss can lead to iron deficiency anemia, as the body’s iron stores are gradually depleted.”
Because it develops slowly, the body might not show symptoms right away. But over time, the anemia gets worse.
Chronic blood loss anemia’s symptoms are often mild at first. You might feel tired, weak, or look pale. Finding it early is key to avoiding serious health issues.
Comparing Recovery Processes
Recovering from acute and chronic blood loss anemia is different. Acute anemia needs quick medical help, like blood transfusions and surgery. Chronic anemia treatment focuses on fixing the cause of bleeding and replacing iron.
Healthcare experts say, “Understanding the cause of anemia is key to effective treatment.” It doesn’t matter if it’s acute or chronic. Finding and fixing the cause is vital for getting better.
In summary, both types of blood loss anemia need special care. Knowing the differences helps doctors give better treatment. This way, patients get the help they need to recover.
Symptoms of Anemia Caused by Blood Loss
Anemia from blood loss shows many symptoms that can be scary. It’s important to know these symptoms can change a lot from person to person.
Early Warning Signs
In the early stages, you might feel your heart beat fast, your skin feel cool, and you might feel very weak. These signs can get worse as time goes on.
Doctors say catching anemia early is key to treating it well. Learning about anemia and its signs is the first step to dealing with it.
Moderate to Severe Symptoms
When anemia gets worse, you might see a big drop in blood pressure, less urine, and harder breathing. You could also feel dizzy or pass out because your body isn’t getting enough blood.
It’s important to remember these signs aren’t just about anemia. They could also mean there’s a bigger problem causing the blood loss.
Emergency Symptoms Requiring Immediate Care
In very bad cases, you might need to get help right away. Look out for very low blood pressure, loss of consciousness, and confusion. These are signs of a serious problem that needs quick help.
If you see these signs in yourself or someone else, get to the hospital fast. Quick action can really help when anemia is severe.
Internal Bleeding and Anemia Development
Internal bleeding can cause a big loss of red blood cells, leading to anemia. This type of bleeding happens inside the body. It can occur in different places like the stomach, belly, or back.
Common Causes of Internal Bleeding
Many things can cause internal bleeding. These include:
- Gastrointestinal ulcers
- Ruptured ectopic pregnancies
- Traumatic injuries
- Vascular malformations
- Cancer
These issues can lead to a lot of blood loss. If not treated quickly, it can lower the red blood cell count. This might cause anemia.
How Internal Bleeding Leads to Anemia
Internal bleeding lowers the number of red blood cells. When blood is lost inside, the body has fewer red blood cells. If the loss is big and new cells aren’t made fast enough, anemia can happen.
The body tries to fix this by changing how it works. It tries to keep enough blood and oxygen flowing to tissues.
Diagnostic Challenges
Finding internal bleeding and its effects, like anemia, can be hard. Symptoms are not always clear, and the bleeding is often hidden. Tests like complete blood counts (CBC), imaging studies (like CT scans), and endoscopy help find where the bleeding is and how it affects red blood cells.
| Diagnostic Test | Purpose |
| Complete Blood Count (CBC) | Check red blood cell count and look for anemia |
| Imaging Studies (CT, Ultrasound) | Find where and how much blood is bleeding |
| Endoscopy | Look at the stomach and intestines for bleeding spots |
It’s key to find and treat internal bleeding early. This helps avoid anemia and other problems. If symptoms don’t get better or get worse, see a doctor right away.
The Myth: Do Anemic People Bleed More?
Many think anemic people bleed more. This idea comes from seeing how severe symptoms are when they do bleed. But the truth is more complex.
Addressing Common Misconceptions
Anemia itself doesn’t make people bleed more. It’s the conditions that cause anemia that might lead to bleeding. For example, someone with iron deficiency anemia from internal bleeding isn’t bleeding because they’re anemic. They’re anemic because they’re bleeding inside.
It’s important to understand this to treat anemia correctly. Anemia means not enough red blood cells or hemoglobin. This makes it hard for the body to carry oxygen. When anemic people bleed, their oxygen problem gets worse, making symptoms more severe.
Why Anemic Individuals Experience More Severe Symptoms When Bleeding
Anemic people might not bleed more, but symptoms can be worse if they do. Their bodies already struggle to carry enough oxygen. Losing more blood makes this harder, causing dizziness, weakness, and shortness of breath.
The main issue is not how fast they bleed but how well their body can handle it. Anemic patients have a harder time coping with blood loss. This makes them more likely to feel the bad effects of bleeding.
The Compounding Effect of Blood Loss in Anemic Patients
Blood loss can have a big impact on anemic patients. When they bleed, their anemia and the blood loss together can quickly make things worse. That’s why quick and good treatment is key.
It’s not that anemic people bleed more; it’s that they have less to spare when they do. Knowing this helps doctors deal with anemia and bleeding better. It helps them get the best results for their patients.
Chronic Bleeding Conditions and Anemia
Chronic bleeding is a big reason for anemia, affecting millions. It happens because of many medical issues. This leads to a loss of red blood cells and anemia. Knowing about these issues helps in stopping and managing anemia well.
Gastrointestinal Sources of Chronic Bleeding
Gastrointestinal problems often cause chronic bleeding. These include:
- Peptic ulcers
- Colon polyps
- Gastritis
- Colorectal cancer
These issues can cause slow, ongoing bleeding. This bleeding might not be seen right away, but it can lead to a lot of blood loss. For example, colon polyps can bleed off and on, while stomach ulcers can bleed all the time if not treated.
| Gastrointestinal Condition | Common Symptoms | Risk of Anemia |
| Peptic Ulcers | Abdominal pain, nausea | High |
| Colon Polyps | Often asymptomatic, rectal bleeding | Moderate |
| Gastritis | Nausea, vomiting, abdominal pain | Moderate |
Gynecological Causes of Chronic Blood Loss
In women, gynecological issues are a big reason for chronic blood loss and anemia. Heavy menstrual bleeding is a big cause, with bleeding that lasts too long or is too much. Other issues, such as uterine fibroids and endometriosis, can also cause chronic bleeding.
The American College of Obstetricians and Gynecologists says menorrhagia affects a lot of women of childbearing age. It can cause iron deficiency anemia if not managed properly.
“Menstrual disorders, including heavy menstrual bleeding, are among the most common causes of iron deficiency anemia in women of childbearing age.”
Other Medical Conditions Associated with Chronic Bleeding
Other than gastrointestinal and gynecological causes, many other medical issues can cause chronic bleeding. These include:
- Cancer (e.g., renal cell carcinoma)
- Bleeding disorders (e.g., hemophilia)
- Chronic inflammatory conditions
These conditions can cause anemia in different ways. This includes chronic blood loss, inflammation, and problems with making red blood cells.
It’s important to know about the many causes of chronic bleeding to diagnose and manage anemia well. By finding and treating the cause of chronic bleeding, doctors can help prevent anemia and improve health outcomes.
Diagnosis of Blood Loss Anemia
Diagnosing blood loss anemia needs a detailed approach. It involves lab tests and imaging studies. Getting the diagnosis right is key to effective treatment.
Laboratory Tests and Findings
Laboratory tests are essential for diagnosing blood loss anemia. A complete blood count (CBC) is usually the first test. It shows hemoglobin levels, hematocrit, and red blood cell indices. More tests might include:
- Reticulocyte count to check bone marrow activity
- Iron studies to see if there’s an iron deficiency
- Stool tests for hidden blood
These tests help doctors understand how severe the anemia is. They also guide further checks to find the cause.
Imaging Studies to Identify Bleeding Sources
Imaging studies are key when the bleeding source is unclear. Endoscopy, colonoscopy, and capsule endoscopy let doctors see the GI tract. They can spot bleeding spots. CT scans and ultrasounds help find internal bleeding or other issues.
Differential Diagnosis Considerations
When diagnosing blood loss anemia, other anemia causes must be considered. This includes nutritional issues, chronic diseases, or bone marrow problems. A detailed medical history and physical exam, along with lab results, help make a correct diagnosis. This ensures the right cause of anemia is found and treated.
Treatment Approaches for Blood Loss Anemia
Managing blood loss anemia needs a few steps. First, find and fix the bleeding source. Then, add red blood cells and help the body heal. Knowing the patient’s condition well is key to good treatment.
Addressing the Underlying Cause of Bleeding
First, find and fix the bleeding source. Tests like endoscopy or imaging might be needed. Once found, stop the bleeding and prevent more.
For example, if it’s a stomach ulcer, medicines can help. They reduce acid and protect the ulcer. For gynecological issues, like heavy periods, hormones, or surgery, might be used.
Blood Transfusions and When They’re Necessary
Blood transfusions are vital for severe cases. They quickly raise red blood cell counts and improve oxygen delivery. The need for a transfusion depends on the anemia’s severity and the patient’s health.
At Liv Hospital, we follow strict guidelines for transfusions. Our team watches patients closely to decide when a transfusion is needed.
| Condition | Blood Transfusion Criteria | Benefits |
| Severe Anemia | Hemoglobin | Rapidly improves oxygen delivery, stabilizes vital signs |
| Acute Blood Loss | Significant ongoing bleeding | Replenishes blood volume, supports organ function |
Iron Supplementation and Other Therapies
Iron is also key in treating blood loss anemia. It helps replace lost iron and supports the body’s ability to make red blood cells.
We offer different iron treatments, like pills or shots, based on what each patient needs. Other help might include vitamins, nutrition advice, and checking howwell the treatment is working.
Innovative Treatment Protocols at Liv Hospital
At Liv Hospital, we use new and effective treatments for blood loss anemia. Our team creates personalized plans for each patient.
We use the latest medical research and technology. This includes advanced tests and treatments to improve patient care.
We aim to give top-notch care for blood loss anemia. Our goal is to help patients recover and get better.
Conclusion
Anemia from blood loss is a serious issue that needs quick action. We’ve looked at how blood loss causes anemia, its symptoms, and why early treatment is key.
At Liv Hospital, we know how complex anemia from blood loss can be. We’re here to give our patients the best care. Our team is ready to offer top-notch healthcare, including treatments for blood loss anemia.
We focus on finding and treating the cause of bleeding. This way, we help patients get better and live better lives. If you’re showing signs of anemia or worry about blood loss anemia, please see a doctor.
FAQ
What is anemia, and how is it related to blood loss?
Anemia is when your body doesn’t have enough healthy red blood cells. This makes it hard for your body to get enough oxygen. Blood loss can cause anemia by reducing the number of red blood cells.
How much blood loss can lead to anemia?
Losing more than 15% of your blood can cause anemia. This includes symptoms like a fast heart rate and low blood pressure. How much blood loss causes anemia can vary based on your health and other conditions.
What are the symptoms of anemia caused by blood loss?
Symptoms can start with early signs like a fast heart rate and cool skin. They can get worse to include low blood pressure and less urine. Severe symptoms like very low blood pressure and loss of consciousness need immediate help.
Can internal bleeding cause anemia?
Yes, internal bleeding can cause anemia. It can come from things like stomach ulcers, ruptured pregnancies, and injuries. Finding internal bleeding can be hard, so doctors need to be careful and use tests.
Do anemic people bleed more than non-anemic individuals?
Anemic people might not bleed more, but they can feel symptoms worse. This is because their bodies can’t carry as much oxygen. Treating blood loss quickly is very important for them.
What are the chronic bleeding conditions that can lead to anemia?
Chronic bleeding can come from many sources. This includes stomach ulcers, colon cancer, and heavy periods. Other medical issues can also cause ongoing blood loss.
How is blood loss anemia diagnosed?
Doctors use tests like blood counts and imaging studies to find the cause. They also look at other possible reasons for anemia. This helps them make a correct diagnosis.
What are the treatment approaches for blood loss anemia?
Treatment includes fixing the bleeding cause, blood transfusions, and iron supplements. Liv Hospital uses new ways to treat anemia. They focus on quality care for each patient.
Can anemia due to blood loss be treated effectively?
Yes, treating anemia from blood loss is possible. It involves fixing the bleeding cause and using treatments like blood transfusions. Quick and effective treatment is key to avoiding problems and improving health.
What is the role of iron supplementation in treating anemia caused by blood loss?
Iron supplements are very important in treating anemia from blood loss. They help replace iron and support the making of new red blood cells. They are often used with other treatments to manage anemia well.
References
- National Institute for Health and Care Excellence (NICE). (2015). Blood transfusion guidelines. https://www.nice.org.uk/guidance/ng24/chapter/recommendations